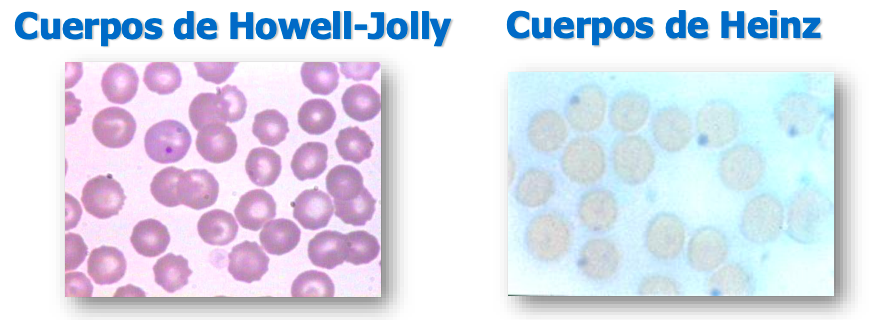
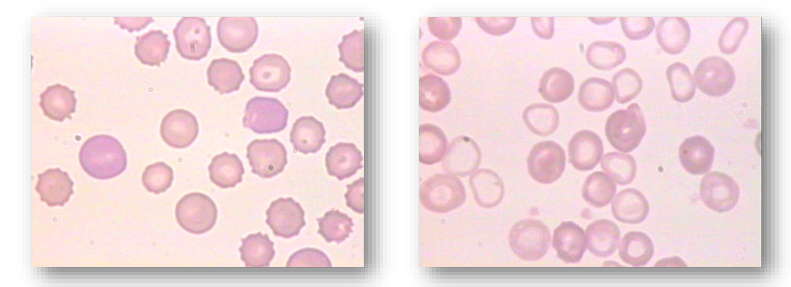

Tema 9 - Sistema Eritroide - 6/10
Clase del 6/10 por Carmen Aceña Fabián Presentación del Sistema Eritroide
PATOLOGÍA GENERAL y PROPEDEUTICA I
Fisiopatología de la sangre
GENERALIDADES
- Sistema eritrocitario
- Sistema leucocitario
- Sistema trombocitario
- Sistema plasmático
SISTEMA ERITROCITARIO
- Eritropoyesis
- Epo → Eritropoyetina
- Fe
- Vitamina B12
- Ácido fólico
EVALUACIÓN LABORATORIAL
1. Parámetros básicos
- Nº hematíes/μl
- Hemoglobina (g/dl)
- Hematocrito (%)
2. Índices eritrocitarios
- VCM → Volumen Corpuscular Medio
- HCM → Hemoglobina Corpuscular Media
- CMHC → Concentración Media de Hemoglobina Corpuscular
Anemia según VCM
- ↑ Aumentado = macrocítica
- = Normal = normocítica
- ↓ Disminuido = microcítica
Anemia según CMHC
- = Normal = normocrómica
- ↓ Disminuido = hipocrómica
- NO HAY HIPERCROMICA YA QUE EL PIGMENTO ESTÁ EN SATURACIÓN
Fórmulas
- VCM = Hto / nº GR × 10 (fl)
- HCM = Hemoglobina / nº GR × 10 (pg)
- CMHC = Hemoglobina / Hto × 100 (g/dl o %)
3. Contaje de reticulocitos
-
(Reticulocitos: glóbulos rojos inmaduros que indican la capacidad regenerativa de la médula ósea.)
-
%
-
Nº absoluto: nº reticulocitos/μl
-
NO PASAN A CIRCULACIÓN EN CABALLOS, no sirve en caballos el contaje de reticulocitos.
Tipos de anemia
- Regenerativa (Si hay mas reticulocitos)
- No regenerativa (Si hay la cantidad normal o incluso menos)
Signos de regeneración - IMPORTANTE
- Macrocitosis
- Policromasia
- Cuerpos de Howell-Jolly
- Eritroblastos
- Punteado basofilo (Mas bien en rumiantes)
- Mas eritrocitos
| Característica | Anemia Regenerativa | Anemia No Regenerativa |
|---|---|---|
| Definición | La médula ósea responde aumentando la producción de GR. | La médula ósea no responde o lo hace de forma inadecuada. |
| Causa principal | Pérdida o destrucción de eritrocitos ya formados (hemorragia, hemólisis). | Producción insuficiente de eritrocitos (déficit nutricional, fallo medular, enfermedad crónica). |
| Contaje de reticulocitos | Aumentado → signo de respuesta regenerativa. | Bajo o normal → ausencia de regeneración. |
| Frotis sanguíneo | - Anisocitosis - Policromasia - Inclusiones (Howell-Jolly, Heinz) - Esquistocitos/esferocitos según causa |
- Microcitosis (ferropénica) - Macrocitosis (megaloblástica) - Hipocromía - Sin policromasia |
| Hemograma | Puede mostrar anemia macrocítica ligera (por reticulocitos grandes). | Anemia persistente sin respuesta regenerativa. |
| Ejemplos (del documento) | - Anemia hemorrágica (aguda/crónica) - Anemia hemolítica (inmunomediada, por cuerpos de Heinz, infecciosa, fragmentación) |
- Anemia por deficiencia de hierro - Anemia megaloblástica (Vit B12 / Ác fólico) - Anemia por enfermedad crónica/inflamatoria - Anemia renal, endocrina, neoplásica - Anemia aplásica |
4. Examen del frotis sanguíneo
Alteraciones en tamaño
- Anisocitosis (variación en el tamaño de los glóbulos rojos)
- Microcitosis (glóbulos rojos más pequeños de lo normal)
- Macrocitosis (glóbulos rojos más grandes de lo normal)
Alteraciones en coloración
- Anisocromía (variación en la coloración de los glóbulos rojos)
- Hipocromía (disminución de la coloración, indica menos hemoglobina)
- Policromasia (presencia de eritrocitos con coloración azulada por inmadurez) muchas veces por presencia de reticulocitos
Alteraciones en forma
Por razones varias
- Poiquilocitosis (presencia de glóbulos rojos de formas anormales)
- Equinocitos o E. crenados (eritrocitos con espículas uniformes en su superficie) A veces ocurre por mal tratamiento de la muestra, vejez o mal estado del material

Por rotura fisica de los eritrocitos
- Acantocitos (eritrocitos con espículas irregulares y gruesas)
- Esquistocitos (fragmentos de eritrocitos, típicos de hemólisis intravascular)
- Esferocitos (eritrocitos redondeados, sin palidez central) Caracteristicos de las anemias hemoliticas inmunomediadas, por anticuerpos antihematies
Otras alteraciones en forma
- Rouleau o pilas de moneda (aglomeración de eritrocitos en columnas, como monedas apiladas) Caracteristicas de enfermedades inflamatorias o hiperproteinemia. FISIOLOGICO en caballo
- Autoaglutinación (aglutinación de glóbulos rojos por anticuerpos) En anemias hemoliticas inmunomediadas
Presencia de inclusiones
- Cuerpos de Howell-Jolly (restos nucleares en el interior de los glóbulos rojos) En anemias regenerayiva, animales sin bazo
- Cuerpos de Heinz (precipitados de hemoglobina desnaturalizada en los eritrocitos)
- Eritroblastos (precursores inmaduros de los glóbulos rojos, con núcleo visible) Generalmente en anemia
- Punteado basófilo (acumulaciones de ARN en los eritrocitos, puntitos basófilos en citoplasma) Se mantiene el nucleo, los eritrocitos pierden flexibilidad
Pagina 13 - Clase del 7/10
5. Examen de Médula Ósea
- Indicaciones de estudio
- Solo los haremos cuando hay una anemias no regenerativas de causas no evidentes o inexplicables. Si es regenerativa sabemos que la medula funciona
FISIOPATOLOGÍA DEL SISTEMA ERITROCITARIO
- Anemia (disminución de la masa de glóbulos rojos o de la hemoglobina circulante)
- Eritrocitosis o Policitemia
ANEMIA
Definición:
La anemia es una afección en la que la sangre no tiene suficientes glóbulos rojos sanos para transportar el oxígeno a los tejidos corporales, lo que puede causar síntomas como fatiga y debilidad. Esto ocurre porque el cuerpo no produce suficientes glóbulos rojos, o porque se pierden o destruyen en exceso.
La velocidad con la que se instaura es importante (Hemorragia es brusca, vejez no)
Signos clínicos
- Mucosas pálidas (no secas, secas es por deshidratación)
- Debilidad
- Intolerancia al ejercicio
Tipos de anemias
Muchas veces las regenerativas tienen peor pronostico que las no regenerativas.
Anemias regenerativas
1. Anemia hemorrágica
-
Aguda
- Definición: condición que se desarrolla rápidamente debido a una pérdida o destrucción significativa de glóbulos rojos como podria ser la causada por una hemorragia.
- Causas: Hemorragia interna (A veces, rotura de un tumor) o externa
- Patogenia:
- Hipovolemia
- Hemodilución
- Anemia NN (normocíticas, normocrómicas)
- anemia MNóH (Microciticas y normocromica o hipocromica)
- Otras modificaciones:
- Hipoproteinemia
- Trombocitosis
-
Crónica Por parasito, errores en la coagulación... A veces no se detectan al principio
- Anemia ferropénica: Mayor causa de anemia ferropenica en adultos es la hemorragia. NO REGENERATIVA Hipoproliferativas
- Definición: Anemia por falta de hierro
- Causas: dietetica o hemorragia (perdida de gran cantidad de hierro)
- Patogenia: Sintomas de anemia
- Anemia normocitica-normocromica + Leucograma inflamatorio
- Anemia ferropénica: Mayor causa de anemia ferropenica en adultos es la hemorragia. NO REGENERATIVA Hipoproliferativas
2. Anemia hemolítica
Clasificación fisiopatológica
- A.H. Extrínsecas:
- Inmunomediada por anticuerpos antihematies
- Por Cuerpos de Heinz
- Infecciosa
- A.H. Intrínsecas
- Defectos enzimaticas
- A.H. Angiopáticas o por fragmentación
- Fallos en los vasos, se rompen los eritrocitos al salir
Inmunomediada
- Etiología: producción de anticuerpos
- Intra o extravascular
- Tipos:
- Primaria (no asociativa) Idiopatico, es decir que no conocemos la causa
- Secundaria (asociativa)
- Signos clínicos Colororación en mucosas, heces, orina. Depende del punto en el que este será rojo en el primer momento, amarillo (Bilirrubina), color marron (Estercobilina). A veces tiene un estado de hipercoagubilidad.
- Biopatología:
- Hiperbilirrubinemia
- Hemoglobinuria
- Bilirrubinuria
El test de Coombs (Hay bastante falsos negativos) Para anemias hemoliticas inmunomediadas.
Hemograma típico
- Anemia severa
- Respuesta regenerativa intensa
- Esferocitosis
- Autoaglutinación
Anemia Hemolítica - Por Cuerpos de Heinz
- Etiología: drogas o agentes oxidantes
- A veces causadas por drogas o agentes oxidantes.
Anemia Hemolítica - Infecciosa
- Etiología: babesia, mycoplasma…
- Más comun
Intrínseca
- Deficiencia de piruvatocinasa
- Deficiencia de fosfofructocinasa
Por fragmentación
- Etiología: CID, hemangiosarcoma
- Esquistocitos visibles (Globulos rojos rotos)
Clase del 14/10
Anemias no regenerativas
1. Deficiencias nutricionales
-
Vit. B12 y Ác. fólico (megaloblástica) Poco comun en animales
- Etiología
- Patogenia:
- Bloqueo síntesis ADN
- “Detención” de división celular
- Disociación desarrollo núcleo/citoplasma
- Anemia macrocítica-normocrómica
-
Hierro (ferropénica)
- Etiología
- Patogenia: aumento divisiones celulares
- Anemia microcítica-hipocrómica
- Test de sangre en heces es muy comun para detectar en colon.
- Generalmente no por falta de hierro en la dieta (En porcino los lechones necesitan aporte), mucho mas comun la perdida de sangre.
- Suelen dar a lugar a una Anemia microcítica y hipocrómica
Clase del 14/10
2. Anemias hipoproliferativas
- La anemia no regenerativa por enfermedad cronica y/o inflamatoria es el principal tipo de anemia en animales o Anemias Hipoproliferativas - IMPORTANTE
- Es causada por un bloqueo de los depositos de Fe o Hierro
- Hierro ferrico bajo en suero, alta la ferrina
- Anemia normocítica-normocrómica + leucograma inflamatorio
- Patogenia: bloqueo de depósitos de Fe
Tipos de anemias hipoproliferativas
- Anemia por enfermedad crónica y/o inflamatoria (Leishmania puede ser esta o renal)
- Anemia de enfermedad renal crónica
- Normocítica-normocrómica
- Patogenia: déficit de Epo
- Anemia de enfermedad endocrina
- Anemia de enfermedad neoplásica
- Anemia de enfermedades parasitarias
3. Anemia aplásica
Por depresión o daño en la medula osea
- Pancitopenia (disminución de eritrocitos, leucocitos y plaquetas)
- Etiología:
- Infecciones
- Drogas (Los citotoxicos, se usan para tratar el cancer)
- Estrogenos
- Mieloptisis, cuando la capacidad de la medula se ve afectada, tejido hematopoyetico se transforma en otros tejidos.) Comun en leucemias, invasión de celulas neoplasicas
- Radiación
POLICITEMIA o ERITROCITOSIS
Definición
(aumento anormal de glóbulos rojos en sangre)
Signos clínicos
Son variables. Valor de hematocrito 70-80% globulos rojos, muy densa y viscosa
Clasificación
-
Relativa = Hemoconcentración
-
Absoluta
- Secundaria
- Aumento compensatorio de Eritropoyetina
- Aumento no fisiológico de Eritropoyetina
- Primaria = Policitemia vera (proceso mieloproliferativo) en perro, gato y conejo
- Secundaria
-
En cabayos el estres puede causarlo. Bazo actua como reservorio de sangre
-
La hipoxia (enfermedades cardiopulmonares, respiratorias cronicas...) puede acabar en una mayor producción de globulos rojos para compensar.
-
Causas de eritrocitosis (NO enfermedades renales, estas generalmente causan anemia), solo algunos tumores que producen eritropoyetinas, o sustancias epo. Sindrome paratoplasico
-
Siempre Eritrocitosis menos en la primaria que se refiere a policitemia (policitemia vera) ya que esta aumenta todos los tipos celulares
Revisar el orden de todo y la clasificacion

No comments to display
No comments to display